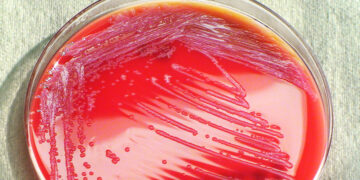

Открыватель антибактериального фермента лизоцима и первого антибиотика пенициллина, как и многие учёные, славился творческим беспорядком в своей лаборатории. Что не только не мешало ему, а напротив, помогло, как известно, получить пенициллин, спасший миллионы жизней.
Ну а увлечение живописью (Флеминг был художником-любителем, членом Клуба искусств Челси) подтолкнуло не чуждого оригинальности учёного создать во время биологических исследований пару «полотен» из разноцветных бактерий. «Холстом» стала лабораторная чашка Петри для выращивания микроорганизмов – стеклянная тарелочка с крышкой, изобретённая в 1877 году немецким бактериологом Юлиусом Петри (Julius Petri), ассистентом знаменитого микробиолога Роберта Коха (Robert Koch).
Конечно, художник-самоучка создавал в этих чашках простенькие картинки, ну да и «красками» ведь служили не акварель или темпера, а живые микроорганизмы.
Выглядело это так: сначала Флеминг изображал будущий рисунок на промокательной бумаге и заливал её в чашке Петри агар-агаром – питательной желеобразной жидкостью. После застывания агара он иглой повторял контуры рисунка, которые одновременно становились барьером для микробов. И засевал культурами бактерий с различными натуральными пигментами, которые отбирал по времени созревания: важно было, чтобы разные виды созревали одновременно, иначе более шустрые размножились бы на чужой территории, смешавшись и разрушив композицию.
Вот с этих рисунков (сейчас они хранятся в лаборатории-музее Александра Флеминга в Лондоне) и берёт начало «бактериальная живопись», или агар-арт. Правда, тогда последователей у «забавы» не нашлось. Не впечатлила мини-выставка «произведений» Флеминга и королеву Марию Текскую, супругу Георга V, во время посещения лондонской церкви Девы Марии. А ведь учёный, разместивший там свой вернисаж, придал им патриотические мотивы!
Зато в наши дни последователей такой техники уже так много, что с 2015 года проводится ежегодный международный конкурс The Agar Art, организованный Американским обществом микробиологии.
На нём учёные из разных стран представляют невероятно красивые произведения из бактериального желе. К примеру, британская художница JoWOnder создала в лаборатории Университета Суррея на манер прерафаэлитской «Офелии» Джона Эверетта Милле (John Everett Millais) цикл «Шесть дней. Прощальные стихи Офелии» – снимки последовательных стадий развития и гибели грибков и бактерий.
А доктор биологии Хантер Коул (Hunter Cole) из чикагского Университета Лойолы создаёт композиции из чашек Петри с посеянными биолюминесцентными бактериями. Она фотографирует их на разных стадиях жизненного цикла – получаются удивительные светящиеся композиции, которые Коул назвала «Биологические домены».
Ну а израильский биофизик, профессор физики из Университета Тель-Авива Эшель Бен-Якоб (Eshel Ben-Jacob, 1952−2015) нашёл уникальный способ направленного выращивания отростков микроорганизмов. В работах учёного-художника колонии сами тянулись своеобразными «усиками» к источнику питательных веществ, в итоге возникали фантасмагорические формы, которые Эшель окрашивал в разные цвета.
Участники конкурса The Agar Art не устают удивлять жюри и зрителей неистощимой творческой фантазией. Так, в 2021 году американский микробиолог Захари Копфер (Zachary Copfer) представил на конкурс копию знаменитого снимка Альберта Эйнштейна (Albert Einstein), созданную методом бактериографии из оранжевой бактерии Serratia marcescens.
«Я микробиолог, выдающий себя за художника. Или я художник, маскирующийся под микробиолога? – размышляет Копфер. – Во время учёбы в аспирантуре я начал использовать искусство как средство, чтобы заново открыть для себя тайны науки, которые когда-то так меня увлекали. Теперь я создаю изобразительное искусство, в котором исследую красоту и поэзию, присущие научным теориям. Мои методы часто представляют собой сплав современного искусства и современной научной практики…»
Миру бактерий посвящён также первый на планете Музей микроорганизмов Micropia в Амстердаме.
Маргарита Дорштейн